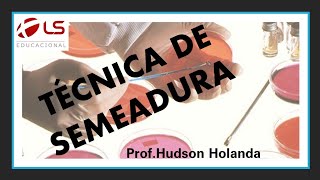

Semeadura em placas
41.96k views625 WordsCopy TextShare

ConectaMicroUFF
Video Transcript:
e aí e aí o olá sejam bem-vindos ao projeto é aulas de bacteriologia hoje vamos apresentar a aula de técnicas de semeadura em placas são métodos pelos quais se transferem óculos bacterianos em um meio de cultura ou material a ser analisado como por exemplo secreções e alimentos para um outro meio e são utilizados para várias finalidades no laboratório de microbiologia dentre elas podemos destacar a contagem bacteriana a visualização de propriedades metabólicas e obtenção de colônias isoladas ou obtenção de crescimento confluente para isso essas técnicas foram divididas em por plate espalhamento esgotamento em estrias essa metodologia
é utilizada quando é necessário realizar a contagem bacteriana podendo também ser utilizada para análise de microrganismos anaeróbios adicionando uma outra camada de meio fundido após o endurecimento da primeira camada entretanto tal método apresenta algumas desvantagens pois os microorganismos sensíveis ao calor podem ser destruí em contato com água fundido no método de por plate um volume de um ml ou 01 ml da diluição bacteriana é depositada diretamente na placa de petri o meio nutriente que é mantido em banho-maria 50 graus para impedir a solidificação do água é vertido sobre a mostra então ela será uma organizada
suavemente com movimentos circulares após a solidificação do meio a placa será encubada em uma estufa bacteriológica para permitir o crescimento das colônias vamos execução método por leite adição do inóculo em placa sem meio com auxílio de uma pipeta adição do larga nutriente fundido homogenizar suavemente com movimentos circulares crescimento das colônias ocorre na superfície do água como também dentro dele e o objetivo do método é obtenção de crescimento confluente ou para contagem bacteriana e pode ser empregado na realização de antibiograma o espalhamento é uma técnica na qual a suspensão bacteriana é adicionada ao meio já solidificado
em placa o inóculo é então espalhado uniformemente sobre toda a superfície do água com auxílio de um espalhador de células chamada alça de drigalski vamos execução método de espalhamento adição binóculo placa contendo meio sólido espalhamento em toda superfície com auxílio da alça desligar o ski espalhador de células crescimento das colônias somente na superfície do meio ó e a semeadura por esgotamento é uma das mais utilizadas no laboratório de microbiologia quando se pretende isolar colônias puras de bactérias em amostras que contém cultura mista de microrganismos para sua realização é necessário colocar um ponto da superfície do
meio de cultura uma alíquota do material com auxílio da alça bacteriológica e espalhar o inóculo em três a quatro sentidos a placa sem recarregá-la de modo a obter quantidades progressivamente menores no material formando dessa maneira colônias isoladas facilitando a identificação das bactérias que cresceram nesse meio a partir disso podem ser observados aspectos macroscópicos das colônias é importante não cruzar as estrias para reduzir o inóculo e obter colônias isoladas pode-se alternativamente flambar a alça entre as estrias e tocar a conta da estria anterior arrastando o pequeno inóculo para a próxima estria vamos execução método de esgotamento
samba na alça de platina para este e esperar esfriar mergulhar a alça no cultivo transferir uma alçada da cultura para o meio sólido em placa estrear a alça bacteriológica sobre o meio a placa é dividido em quatro quadrantes a inoculação é realizada estreando metade da placa com movimentos de zig-zag jirau a 90° e estrear até a metade um quarto da placa feito esse procedimento girar mas 90 graus e estrear o meio restante atenção todas as técnicas apresentadas devem ser realizadas na zona de segurança do bico debussy e durante a realização dos procedimentos não se deve
falar para evitar a contaminação do seu trabalho e espero que tenham gostado até a próxima vídeo aula de bacteriologia e e aí e aí
Related Videos

4:56
Semeadura em tubos
ConectaMicroUFF
10,807 views

27:46
Meio de cultura (3/3): técnicas de semeadura
Fabíola Dorneles
5,039 views

1:09:42
Bactérias Marinhas: diversidade e estratég...
ConectaMicroUFF
186 views

59:46
Preparação de meios de cultura em placas d...
PROF. MAYER
27,753 views

29:26
Aula Pratica 5 - Técnicas de isolamento de...
Caio Rachid
4,800 views

20:25
Videoaula 2 - Semeadura e crescimento de m...
Fernando Freitas
15,944 views

5:13
Teste de Sensibilidade Antimicrobianos - ...
ConectaMicroUFF
16,167 views

26:18
Microbiologia de Alimentos: Técnica de Pla...
Prof Marina Copetti
8,453 views

10:21
Três meios de cultura usados na MICROBIOLO...
MicroClass do Marcelo Oliveira
3,720 views

50:11
Sequenciamento de DNA: do Sanger as novas ...
ConectaMicroUFF
126 views

6:34
Microbiologia: Semeadura bacteriana
Saúde Na Veia
4,453 views

25:17
Microbiologia de Alimentos: Técnica de Pla...
Prof Marina Copetti
17,109 views

28:52
Métodos Analíticos de Microbiologia de Ali...
Cris Zaicovski
38,703 views

5:59
TÉCNICAS DE SEMEADURA EM MEIO SÓLIDO, NA P...
Renata Aquino - Do Básico ao Clínico
30,941 views

45:08
Aula Pratica 1 - Material e técnicas util...
Caio Rachid
17,316 views

40:32
Microbiologia Médica: Principais Meios de ...
CS Ciências da Saúde
28,043 views

38:06
Inoculação de Microrganismos
Dra. Carla Leite - Vídeos de Microbiologia
2,582 views
20:14
Técnica de semeadura
Hudson Holanda
3,405 views

11:50
MEIOS DE CULTURA EM MICROBIOLOGIA - PROF. ...
Alexandre Funck
50,537 views

28:50
Aula prática - Os microrganismos estão em ...
PROF. MAYER
30,328 views